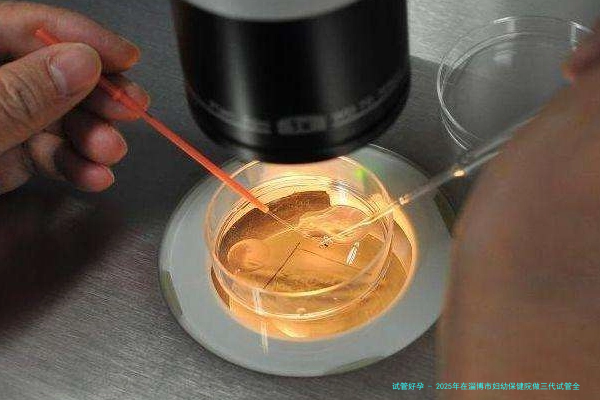

2025年在吉林省妇幼保健院做试管婴儿的总费用大约在3万到5万元人民币左右。这其中包括前期检查费用、促排卵药物费用、手术费用来及胚胎移植后的黄体支持药物费用等。详细费用会因各别差别、用方子案以及是否需
吉林试管婴儿 第三代试管婴儿 49分钟前·49人浏览 苏大附二院做三代试管婴儿9万够吗?在苏大附二院做三代试管婴儿,预备九万块钱可能不够。根据现在的情况来看,三代试管婴儿的费用平常在8万到12万元之间,具体费用会因个人情况和用方剂案而有所差异。9万元的估算可能需要您位于一些环节上进行一丝不苟
第三代试管婴儿 3小时前·14人浏览 宁德闽东医院三代试管婴儿具体花费高吗?在宁德闽东医院做三代试管婴儿,总体的花费其实不算低。一般来说,整个过程的花费大概在八万到十二万元块钱之间。这其中包含了术前检查、诱导排卵药物、采卵手术、胚胎培育、基因筛选诊断(PGD/PGS)、胚胎移植
湖南省人民医院的三代试管费用其实不算低,但也在可接纳范畴内。一般来说,1个周期的总费用大概在八万到1两万人民币之间。具体费用会因个人情况、用方子案以及是否需要额外检查等因素而有所差异。三代试管婴儿的
湖南试管婴儿 第三代试管婴儿 1天前·11人浏览 厦门市妇幼保健院做第三代试管婴儿具体花销有哪些明细?在厦门市妇幼保健院做第三代试管婴儿,总价格大约在6万元到十万块之间,主要包括下面列举几个方向的费用:厦门市妇幼保健院第三代试管婴儿费用明细以下是厦门市妇幼保健院第三代试管婴儿可能牵涉的费用明细,详细费用
厦门试管婴儿 第三代试管婴儿 1天前·30人浏览 在杭州妇幼做三代试管婴儿各项花费明细有哪些?在杭州市妇幼保健院做三代试管婴儿,总价格大概在五万到10万元元钱之间。具体费用会因个体情况、用方子案和胚胎筛选数量等要点有所差别。关键的费用项目囊括:1.术前检查费用:夫妻两边都须要进行全方位的身体检
杭州试管婴儿 第三代试管婴儿 2天前·41人浏览 2025沈阳三代试管助孕花费详情,预算安排一清二楚迈步踏上三代试管婴儿助孕的路程,关于众多渴望具有健康婴儿的家庭而言,这不仅是1段充满希望的医药学探索,更是一项须要周密计划的严峻决定。特别是在费用方向,清晰的预算安排是确保全部过程顺利进行的重点。在沈阳,2025年进行三代试管助孕,其总花销预计会在十万块至18万元块钱之间浮动,这其中囊括了从起始检查到胚胎移植及后期管理等多个环节。
沈阳试管婴儿 第三代试管婴儿 21小时前·45人浏览 2025年山西第三代试管婴儿大概花多少钱?真实费用记录和流程一览!面对2025年的生育计划,许多家庭将目光投向了领先的辅助生育技术,其中第三代试管婴儿(PGT)以其特殊的优势,为有特殊遗传需求的家庭带来了新的期望。在山西,进行一次完善的第三代试管婴儿周期,预计总价格大约在10万元到18万元块钱之间,这包括了从术前检查到胚胎移植及后续支持的各项花费,具体金额会根据个人情况和所挑选方案有所浮动。
山西试管婴儿 第三代试管婴儿 1天前·9人浏览 2025年安徽省三代试管婴儿花费明细 流程介绍与重要事项在追求完善家庭的路程上,当代医疗学为诸多不孕不育家庭带来了希望的曙光,其中,第三代试管婴儿技术(PGT)以其精准筛选胚胎遗传欠缺的优势,成为很多特定需求家庭的首选。对于谋划在2025年于安徽省接受此项助孕技术的家庭而言,了解其详细消费、完备流程以及关键注意事情,无疑是走向成功的第一步。本文将深入解析2025年安徽省三代试管婴儿的相关信息,力求为您提供一份明了、全方位的指南。
安徽试管婴儿 第三代试管婴儿 2天前·10人浏览 南京第三代试管婴儿攻略:想省钱的必看这篇!至于许多渴望拥有健康宝宝的家庭而言,第三代试管婴儿技术(PGT,胚胎移植前遗传学检查)必定带来了新的期望。然而,这项领先技术所牵涉的费用也让不少家庭望而生畏。在南京进行1次完整的第三代试管婴儿疗程,总费用大约在10万到十五万元人民币之间,乃至可能更高,详细取决于个人情况、选择的医院以及治疗方案的复杂程度。
南京试管婴儿 第三代试管婴儿 2025-09-27·15人浏览 2025年山西省太原第三代试管婴儿一次全程需要多少钱,完整罗列各项费用明细与构成随着医学科技的飞速发展,辅助生育技术为很多家庭带来了生育的希望。在山西省太原市,愈来愈多的家庭开始留意第三代试管婴儿技术(PGT),即胚胎植入前遗传学诊断/筛查,以此期望生育健康的宝宝。然而,这个前沿技术也伴跟着不菲的经济加入。
山西试管婴儿 第三代试管婴儿 2025-09-26·25人浏览 江苏南京三代试管助孕全环节说明/费用标准及主要优势呈现江苏南京三代试管助孕全环节说明、费用标准及主要优势呈现随着医疗学技术的连续发展,试管婴儿技术已经帮助众多难育家庭达成了生育梦想。在江苏南京,三代试管婴儿技术以其更高的成功率和更普遍的适用情况,受到了越发越多患者的青睐。本文将为您细致说明南京三代试管婴儿的全环节省程、费用尺度以及主要优势,协助您更好地认识这个技术,给您的生育之路提供参考。
江苏试管婴儿 第三代试管婴儿 2025-08-31·102人浏览


